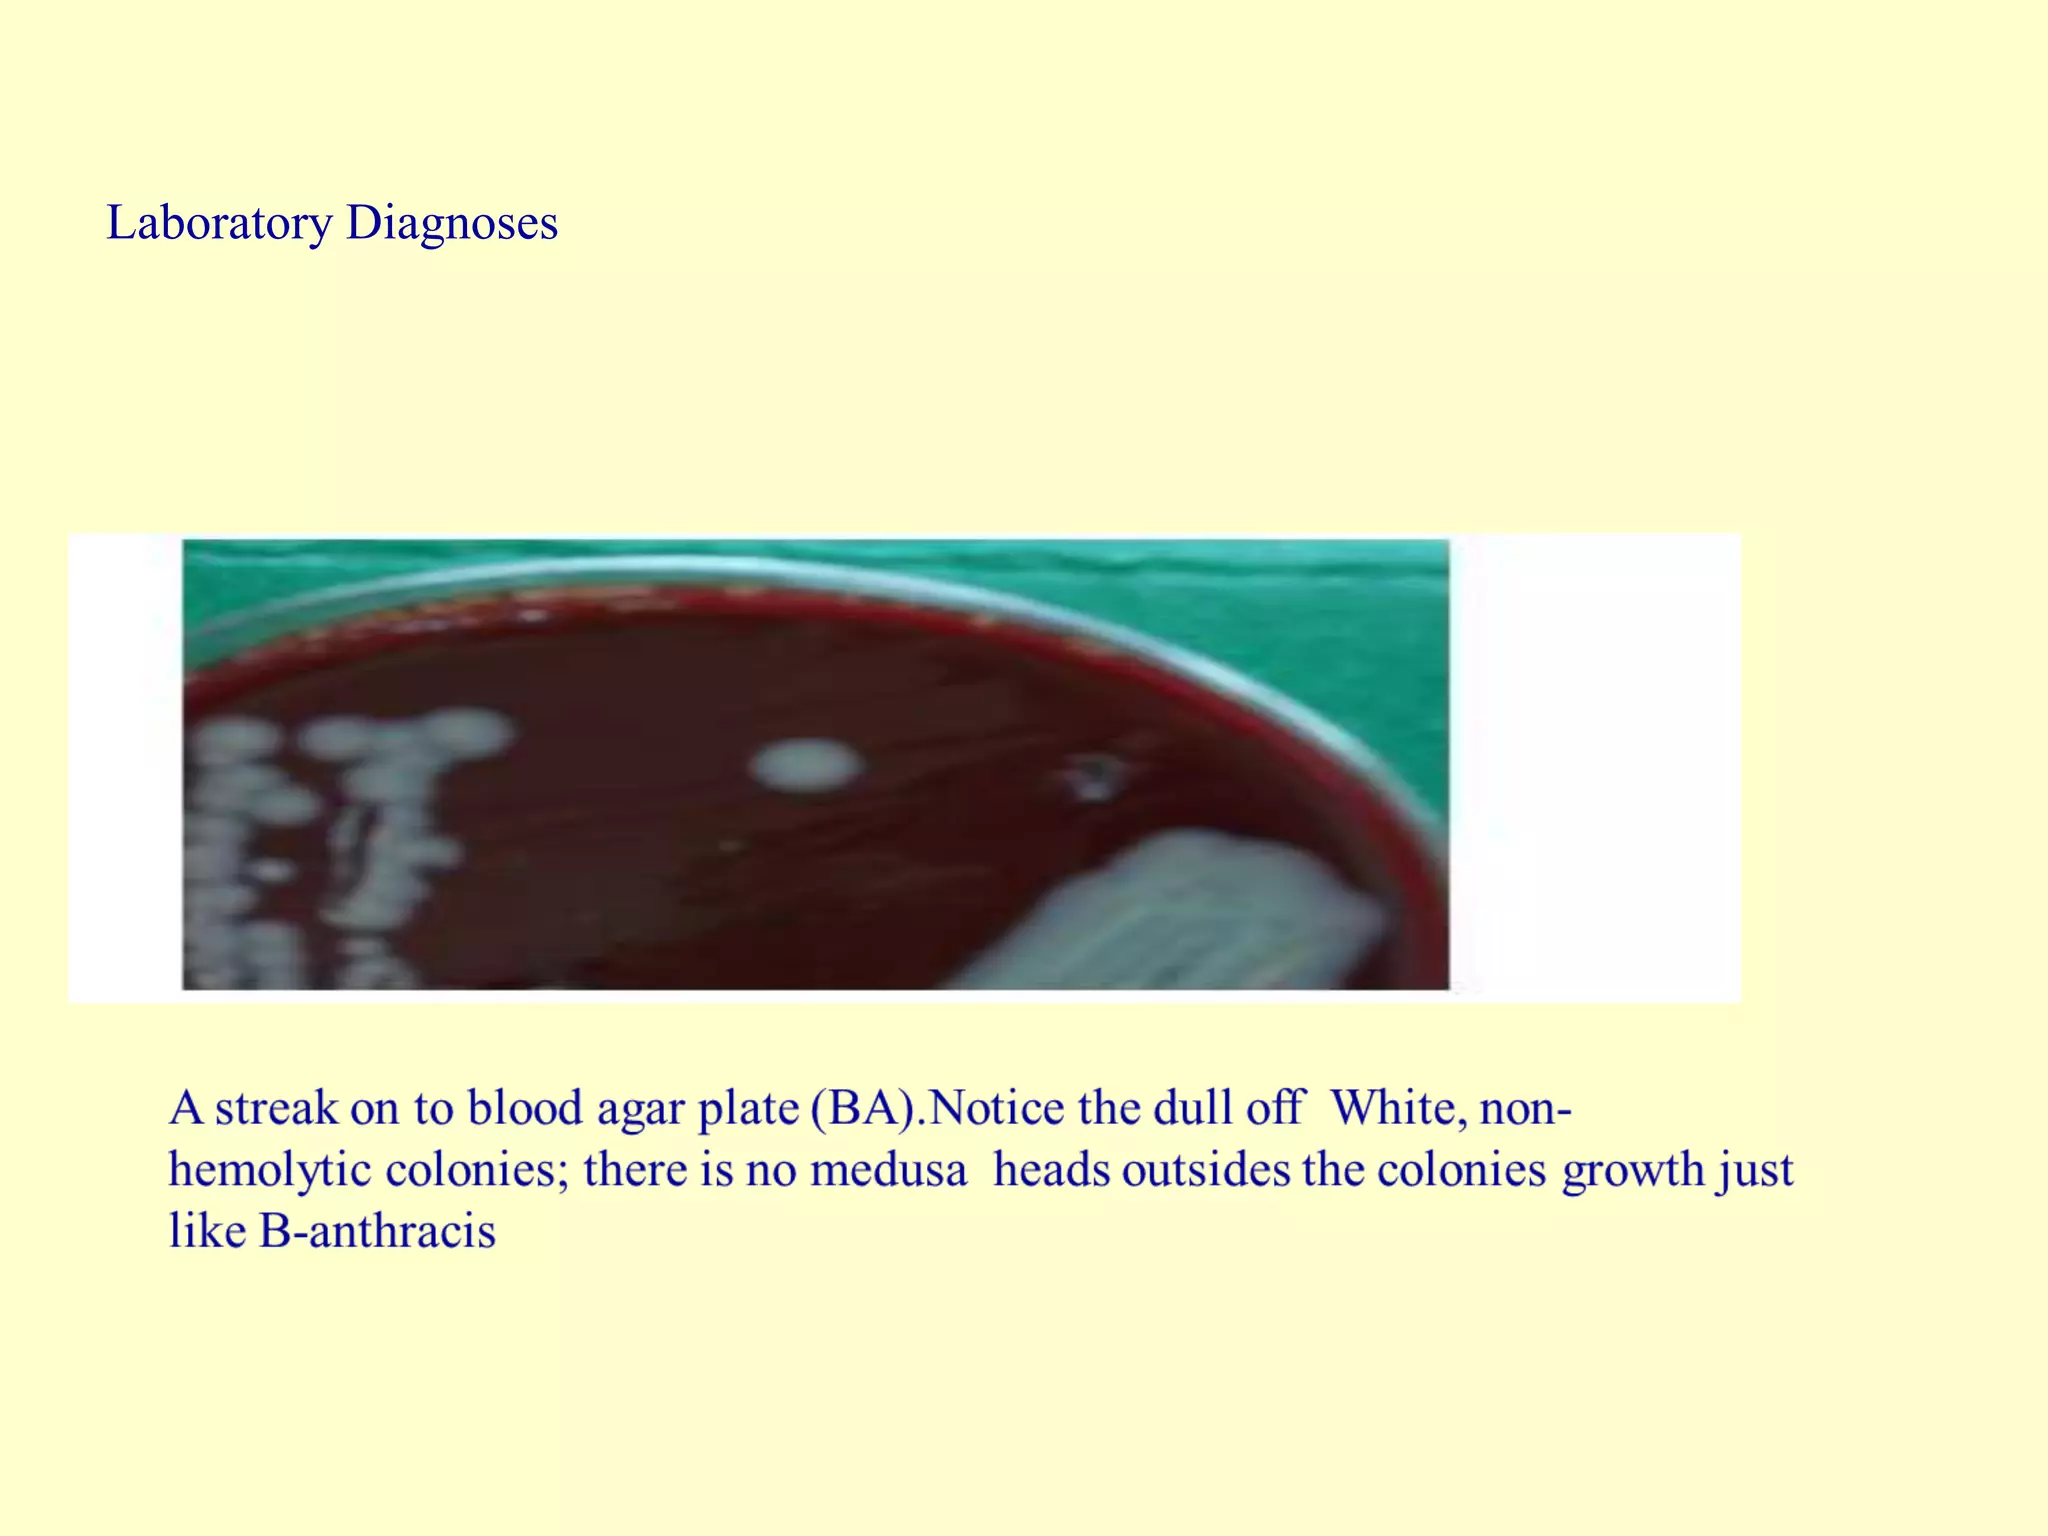
Laboratory Diagnoses
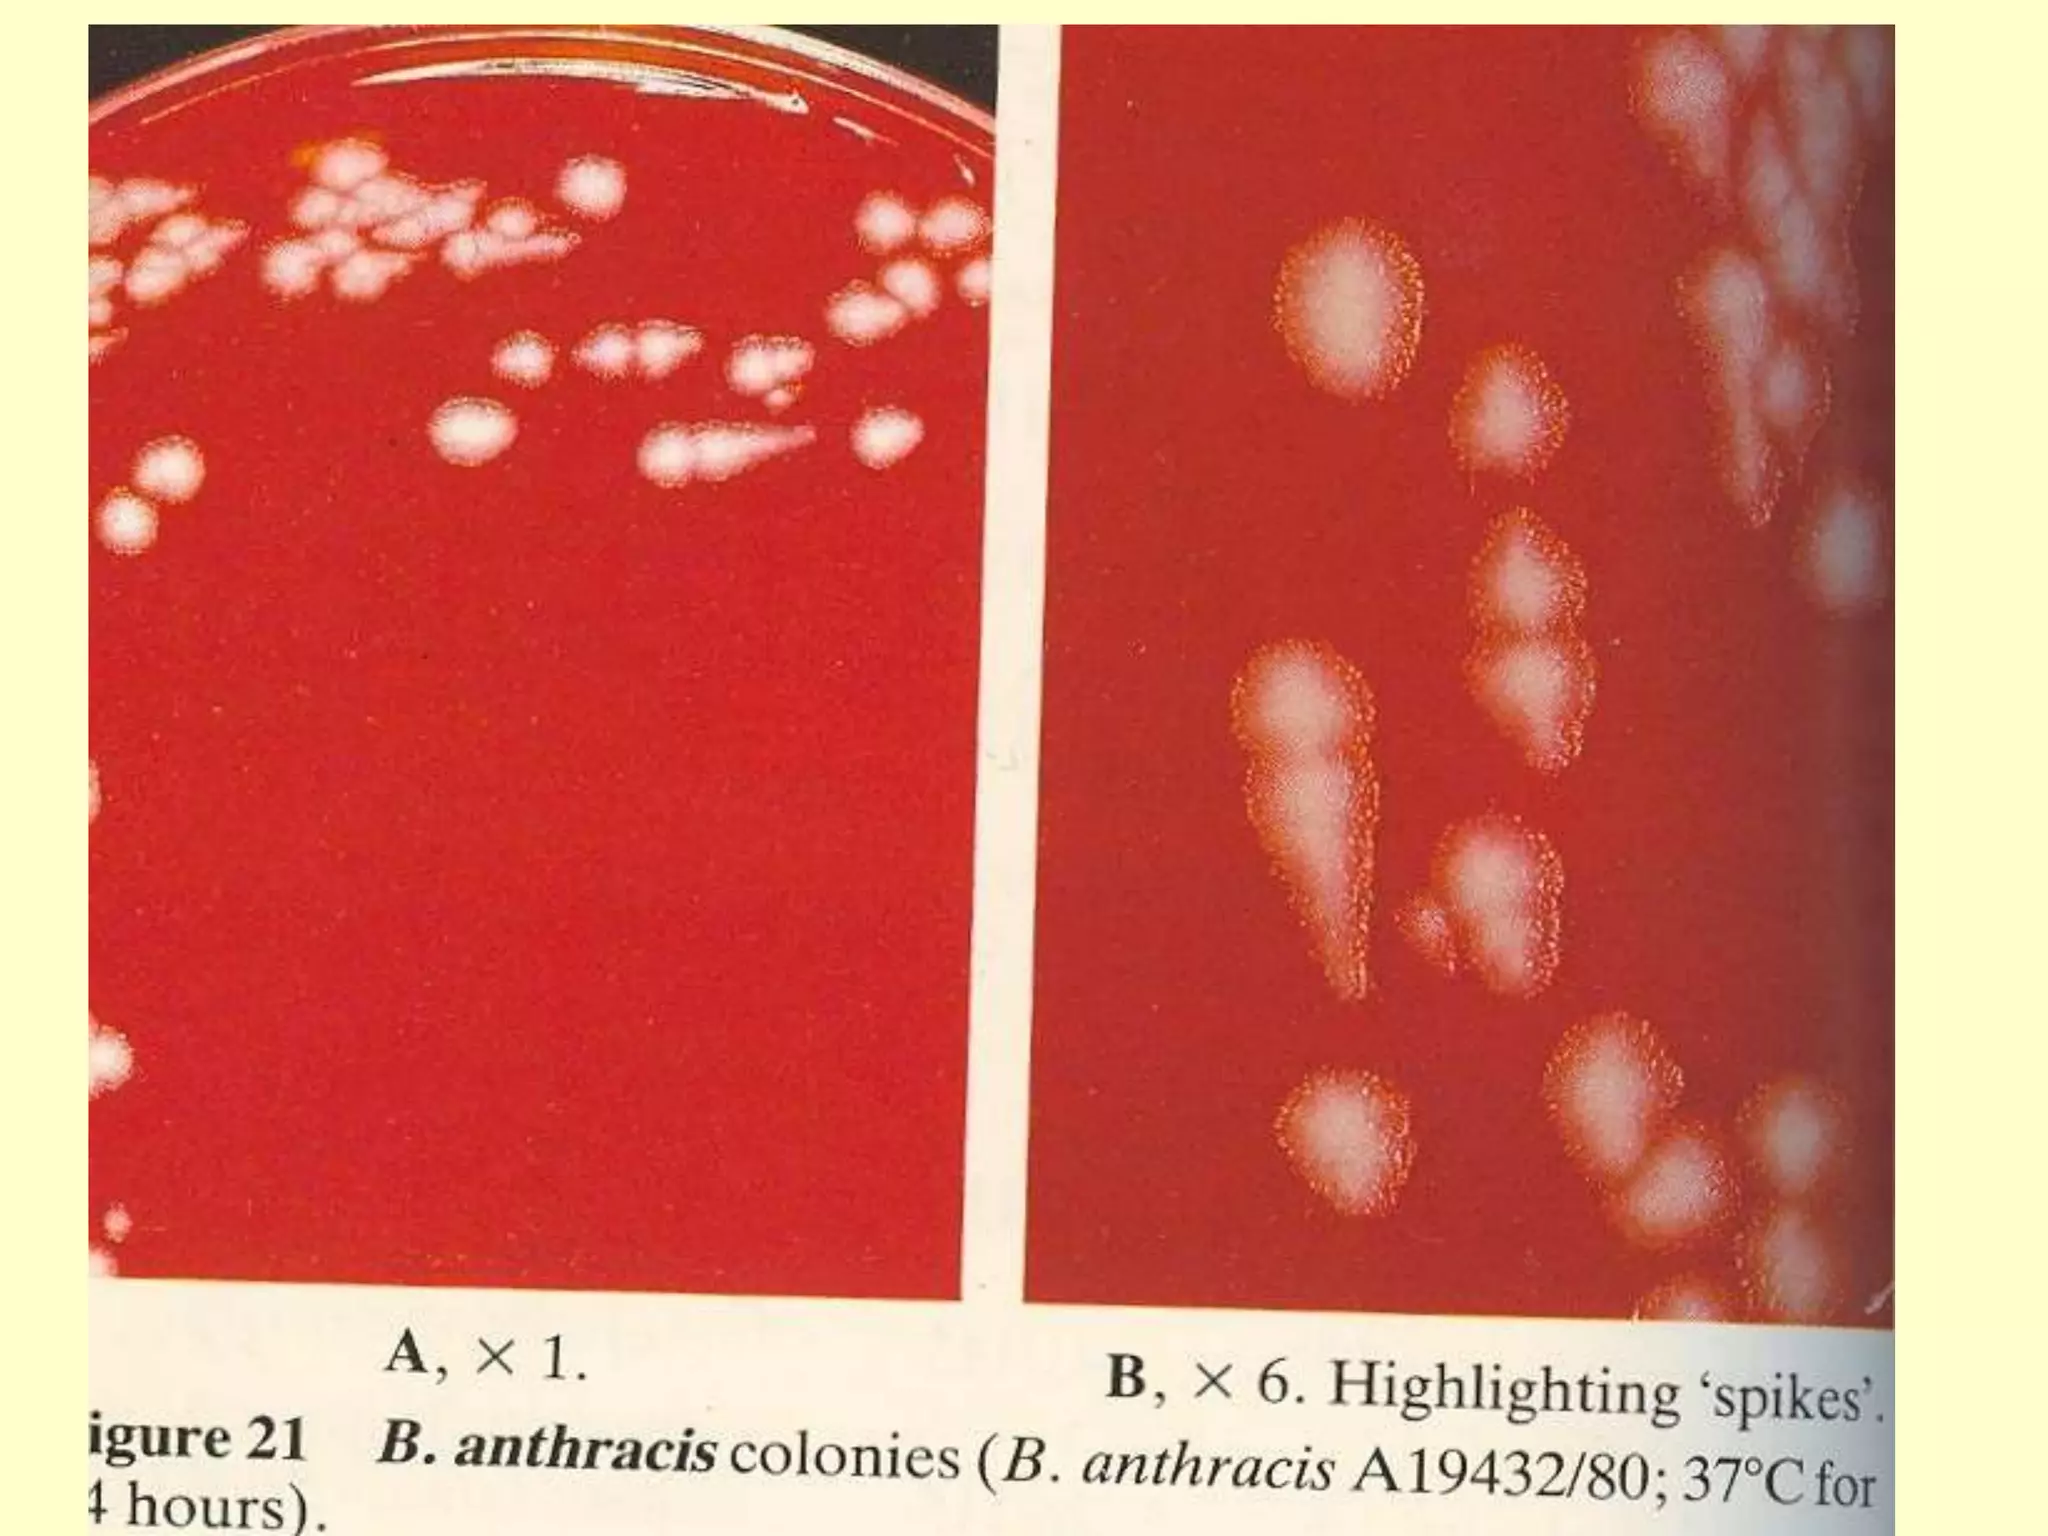
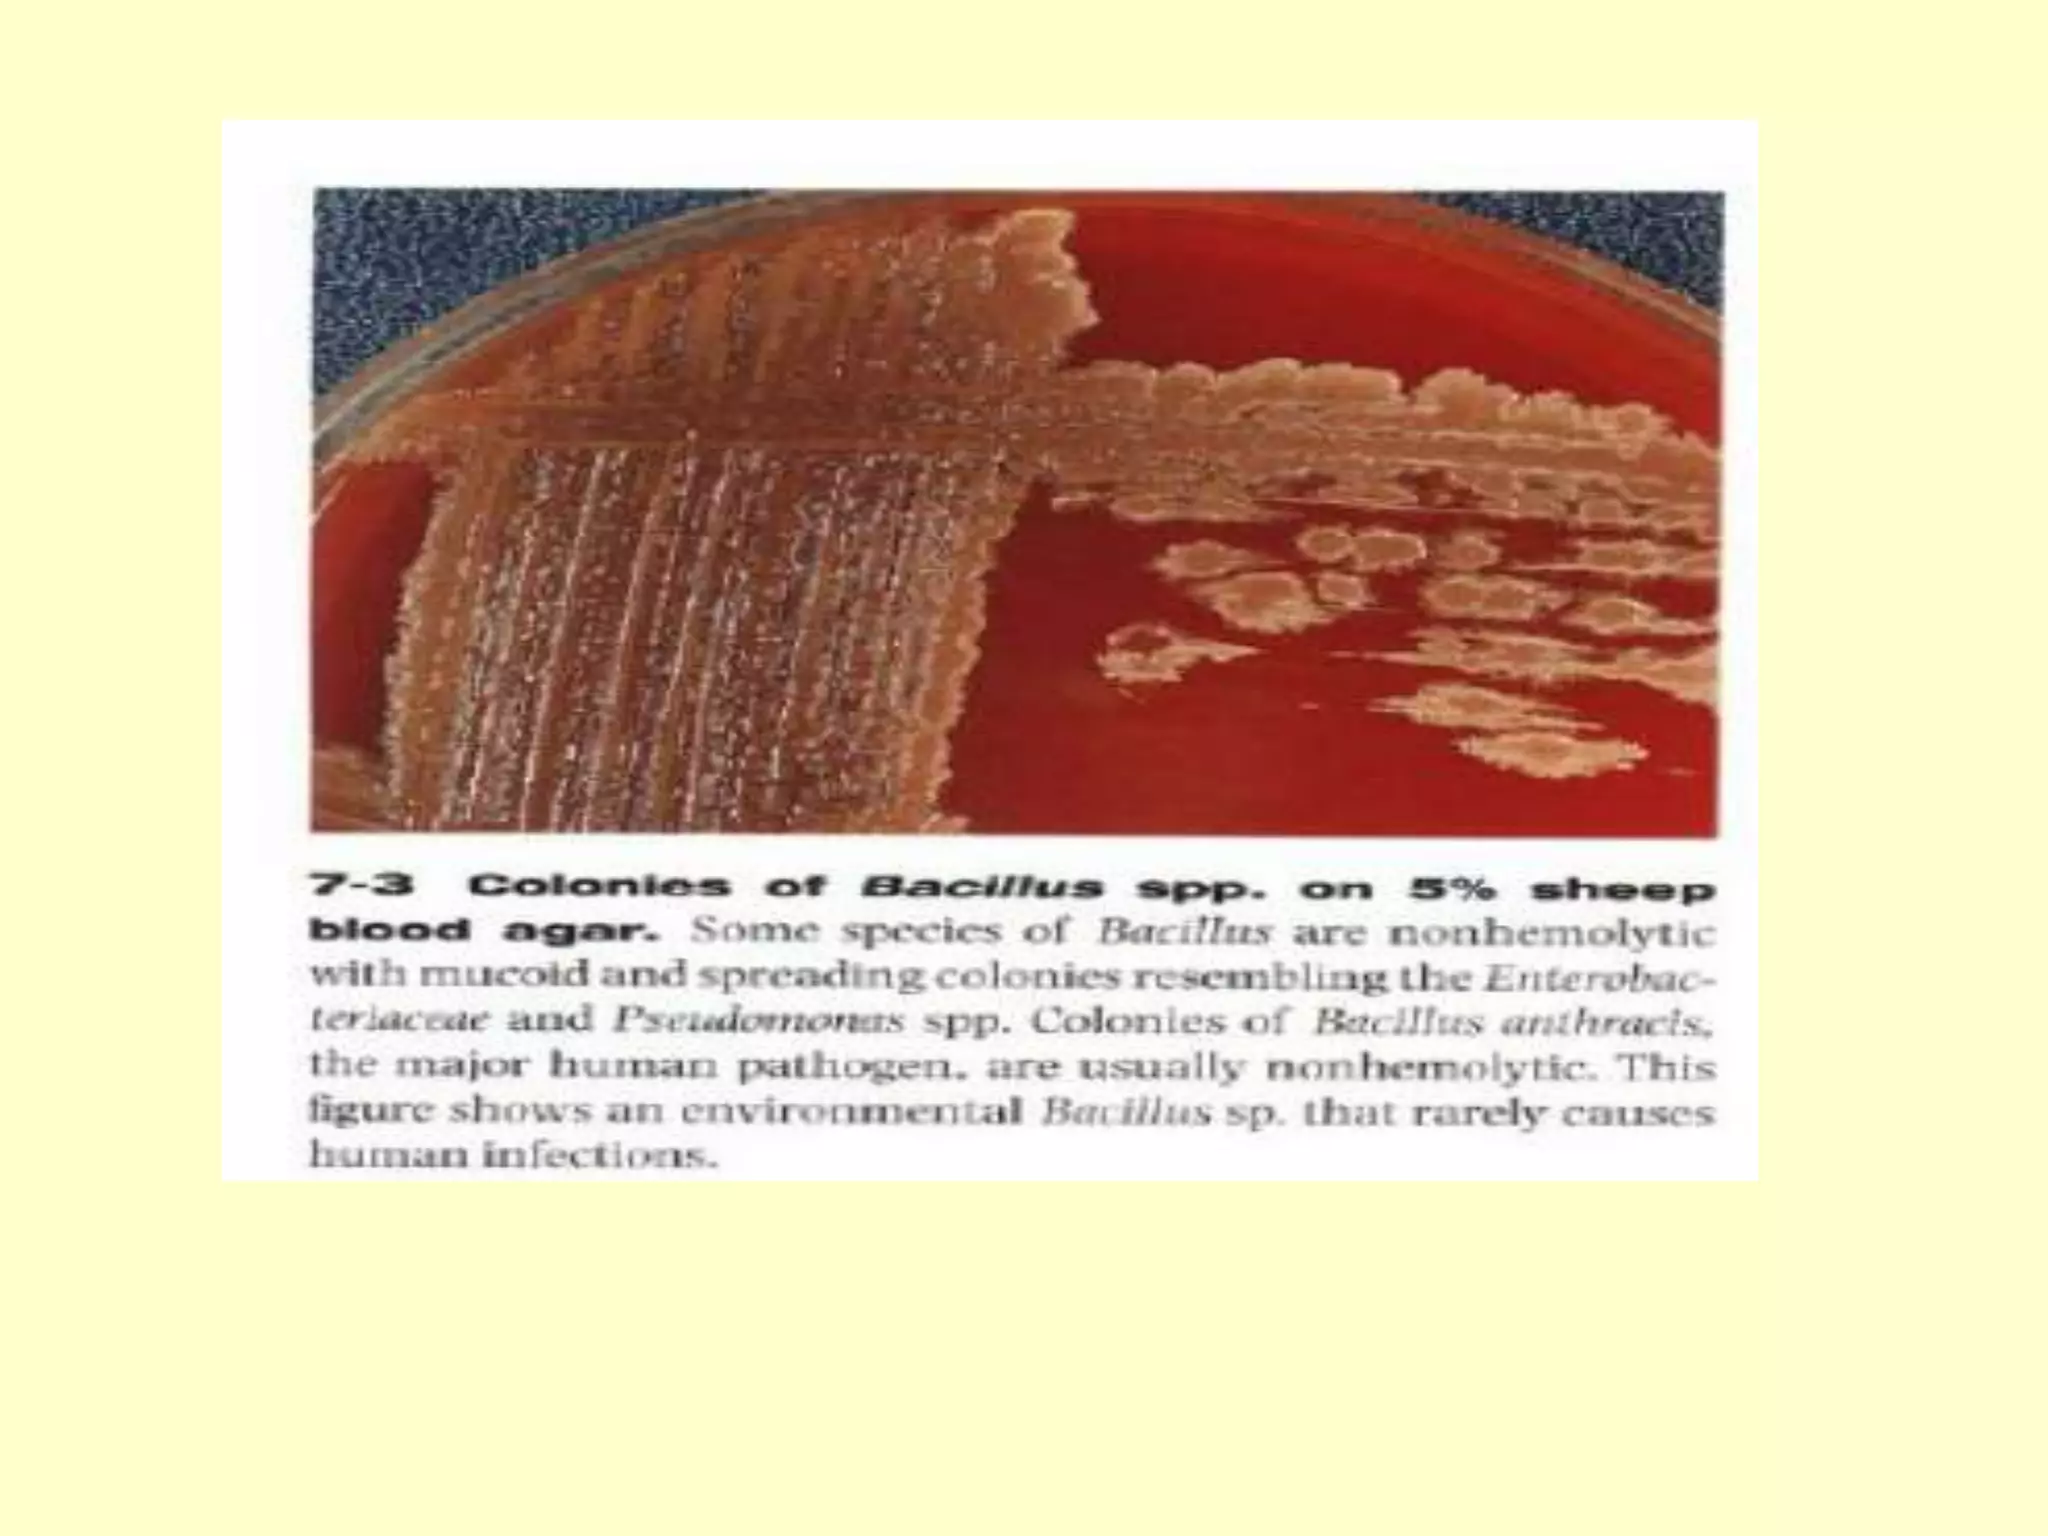

Bacillus anthracis, Clostridium, Corynebacterium, Listeria, and Lactobacillus are important Gram-positive bacilli. B. anthracis causes anthrax in humans and animals. It forms spores that allow transmission. Anthrax infections can occur cutaneously, by inhalation, or gastrointestinal routes with varying mortality rates. Laboratory identification of B. anthracis involves culture, Gram stain showing characteristic morphology, lack of hemolysis and motility compared to Bacillus cereus. B. cereus can cause two types of food poisoning.